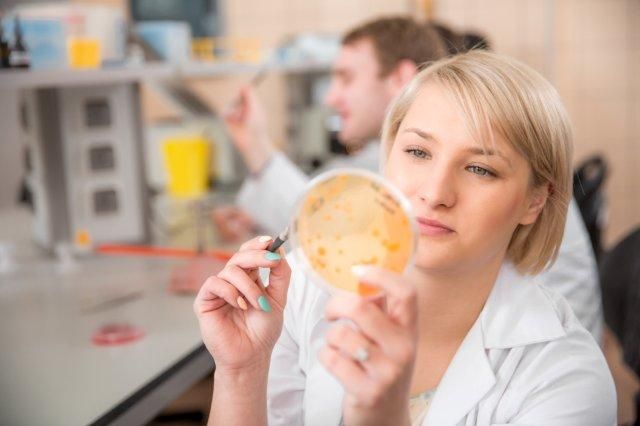

Archiwum aktualności
Warsztaty i Seminaria - ZRÓWNOWAŻENI II
przez Edito Administrator
Katedra Biologicznych Podstaw Rolnictwa i Edukacji Środowiskowej Uniwersytetu Rzeszowskiego
Południowo-Wschodni Oddział Polskiego Towarzystwa Inżynierii Ekologicznej w Rzeszowie
Wojewódzki Fundusz Ochrony Środowiska i Gospodarki Wodnej w Rzeszowie
Studenckie Koło Naukowe Zrównoważonego Rozwoju
zapraszają wszystkich zainteresowanych, w tym uczniów szkół ponadgimnazjalnych Podkarpacia i ich nauczycieli do wzięcia udziału w SEMINARIUM i WARSZTATACH:
ZRÓWNOWAŻENI II
Spotkanie odbędzie się w auli Wydziału Biologiczno-Rolniczego Uniwersytetu Rzeszowskiego w sali 108 budynku D9, ul. Zelwerowicza 4,
w dniu 13 kwietnia 2016r. (środa) o godz. 9.00.
(dojazd na miejsce autobusem linii 18, 5 i 19)
Działamy zgodnie z Dekadą Różnorodności Biologicznej (przypadającą na lata 2011-2020), pogłębiając podstawy edukacji ekologicznej i wdrażania zrównoważonego rozwoju w codziennych działaniach.
Zaprezentujemy bardzo aktualny społecznie temat terroryzmu i związanych z nim szeroko pojętych zagrożeń dla człowieka i przyrody.
Program Spotkania:
- "Zagrożenia nadzwyczajne w kontekście środowiskowym"– prof. dr hab. Joanna Kostecka
- „Zagrożenia CBRN - możliwości Krajowego Systemu Ratowniczo-Gaśniczego województwa podkarpackiego” – st. bryg. mgr inż. Jan Ziobro - Zastępca Podkarpackiego Komendanta Wojewódzkiego Straży Pożarnej
- Warsztaty „Zgaś ryzyko” – st. kpt. mgr inż. Grzegorz Wójcicki - Komenda Miejska Państwowej Straży Pożarnej w Rzeszowie
przerwa
- „Algorytm postępowania w przypadku zagrożenia bombowego” – st. asp. Piotr Urban - Komenda Wojewódzka Policji w Rzeszowie
-
Warsztaty „Pokaz sprzętu minersko-pirotechnicznego” – st. asp. Piotr Urban -
Komenda Wojewódzka Policji w Rzeszowie
- Konkurs wiedzy wyniesionej ze spotkania (z nagrodami dla chętnych słuchaczy przeprowadzonych zajęć)
Udział w spotkaniu jest bezpłatny
Dodatkowe informacje:
Katedra Biologicznych Podstaw Rolnictwa i Edukacji Środowiskowej, Uniwersytet Rzeszowski
35-959 Rzeszów, Ćwiklińskiej 1A
e-mail: sekzppr@ur.edu.pl tel: 0178721728
Prosimy o potwierdzenie udziału w Warsztatach na załączonym formularzu do dnia 8.04.2016. na adres: sekzppr@ur.edu.pl oczekując potwierdzenia zgłoszenia